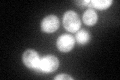
YBL056W
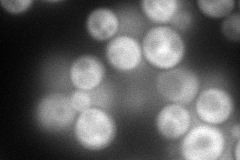
YBL056W
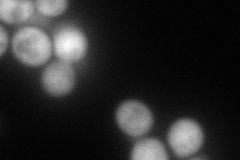
YBL056W
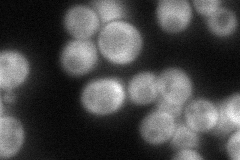
YBL056W
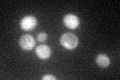
YBL056W

View description
Type 2C protein phosphatase; dephosphorylates Hog1p (see also Ptc2p) to limit maximal kinase activity induced by osmotic stress; dephosphorylates T169 phosphorylated Cdc28p (see also Ptc2p); role in DNA checkpoint inactivation
Localization:
Intensity:
Fold change:
Significance:
-
C’ GFP library in SD
cytosol100.84 -
N' NOP1pr-GFP in SD
cytosol139.885 -
N' TEF2pr-mCherry in SD
cytosol224.882 -
N' NATIVEpr-GFP in SD
cytosol93.2783 -
N' TEF2pr-VC and Cyto-VN in SD

#N/A0 -
C’ GFP library in SD+DTT

cytosol119.251.18No -
C’ GFP library in SD+H2O2

cytosol95.380.94No -
C’ GFP library in Starvation Media
cytosol65.920.65Yes -
C’ GFP library on the background of Pup2-DaMP

cytosol -
C’ GFP library on the background of CCT mutant

cytosol107.2671.06363No
